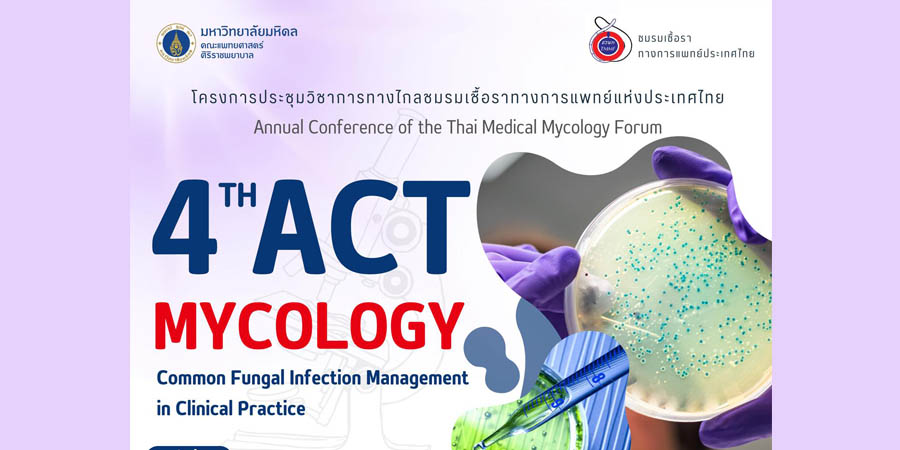
spor2
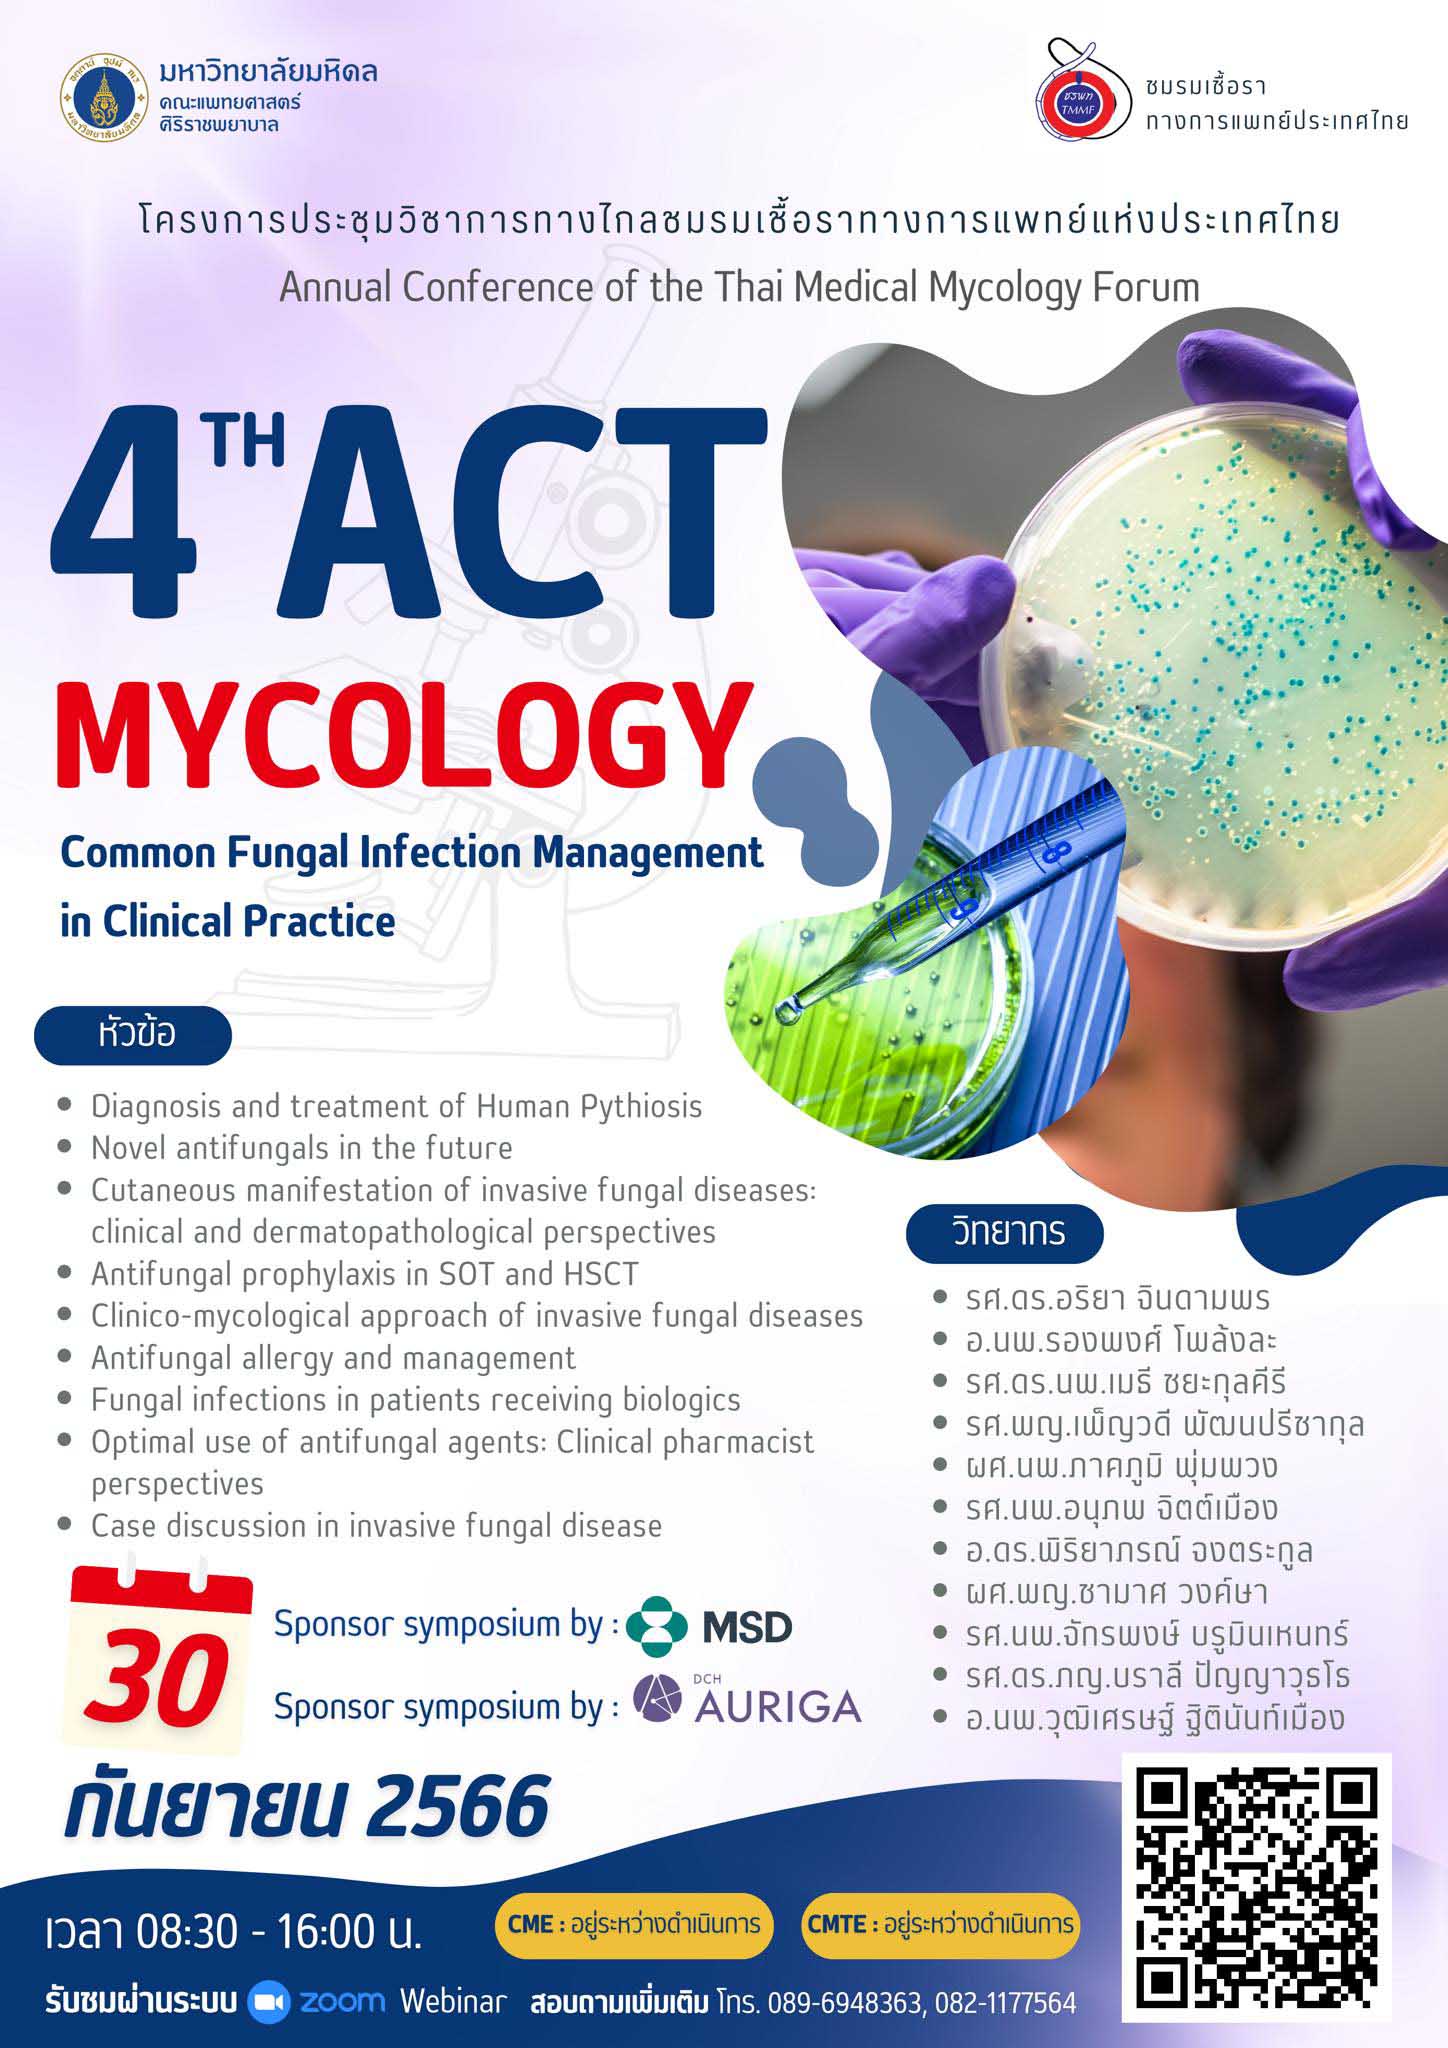

Online , 30 กันยายน 2566
ชมรมเชื้อราทางการแพทย์ประเทศไทย จัดโครงการประชุมวิชาการทางไกลชมรมเชื้อราทางการแพทย์ประเทศไทย Annual Conference of the Thai Medical Mycology Forum : 4th ACT Mycology (Common Fungal Infection Management in Clinical Practice) วันที่ 30 กันยายน 2566 รูปแบบ Online ผ่านระบบ Zoom Webinar
ผู้สนใจลงทะเบียนสามารถ Scan QR Code ในโปสเตอร์งานประชุม หรือ
https://sites.google.com/mahidol.edu/mycology/
สอบถามรายละเอียดเพิ่มเติมได้ที่
โทร.089 694 8363, 082 117 7564